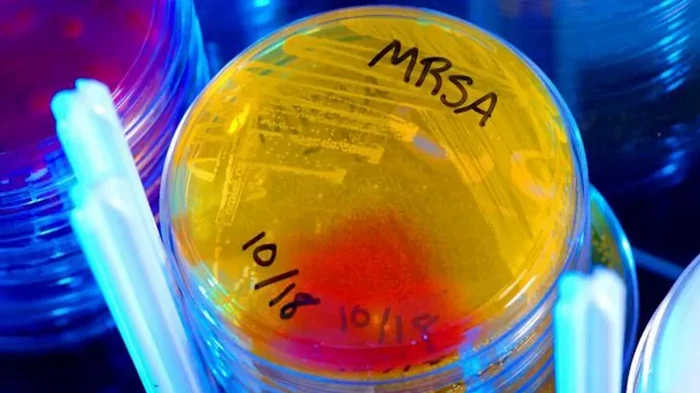

Найден новый антибиотик, способный лечить опасные инфекции: все время скрывался на виду | |
|
Химики заявили об открытии первого представителя нового перспективного класса антибиотиков
В новом исследовании ученые обнаружили ранее не встречавшийся антибиотик. Результаты предварительного исследования показали, что он может быть особенно полезным в лечении лекарственно-устойчивых инфекций. Химики заявили об открытии первого представителя нового перспективного класса антибиотиков — открытие стало неожиданностью, поскольку авторы исследования не ставили перед собой задачу поиска новых лекарств, пишет Live Science. Открытие антибиотика нового поколенияПо словам команды, новый антибиотик демонстрирует многообещающую активность против лекарственно-устойчивых инфекций, в том числе:
По словам ведущих авторов исследования, химиков Лона Альхалафа и Грега Чаллиса, об открытии новой молекулы они сообщили в своей статье, опубликованной в журнале Американского химического общества. Впрочем, изначально целью команды вовсе не было открытие новых лекарств — на самом деле ученые изучали. Как известный антибиотик, метиленомицин А, синтезируется почвенной бактерией Streptomyces coelicolor. Известно, что растения и микроорганизмы производят множество сложных соединений, называемых вторичными метаболитами. Многие из них на самом деле обладают полезными лечебными свойствами для человека. Именно поэтому, понимание того, как эти соединения синтезируются в этих организмах и как они взаимодействуют с клетками человека, на самом деле может помочь ученым разрабатывать эффективные лекарства на основе этих природных продуктов. По словам ученых, программы для производства этих различных молекул хранятся в определенных группах генов, известных как "биосинтетические генные кластеры". В своем исследовании химики удаляли отдельные гены из этих кластеров, что позволило им удалить специфические ферменты, участвующие в синтезе метиленомицина А. Этот метод позволил ученым останавливать последовательность реакций в ключевых точках для более детального изучения, а также точечно выделять не наблюдавшиеся промежуточные соединения, образующиеся в ходе этого процесса. В результате ученым удалось выделить две ранее не встречающихся молекулы, которые они назвали пре-метиленомицином С и пре-метиленомицином С лактоном. Ученые также использовали разные методы, что позволило исследовать биологическую активность молекул в отношении ряда бактериальных штаммов. Эффективность нового антибиотикаПо словам Чаллиса и Альхалафа, пре-метиленомицин С лактон оказался невероятно перспективным — он активен против ряда грамположительных бактерий, включая метициллин-резистентный золотистый стафилококк (MRSA) и полирезистентный штамм Enterococcus faecium. Более того, результаты указывают на то, что новый антибиотик в 100 раз эффективнее в уничтожении лекарственно-устойчивых бактерий, чем исходный антибиотик. Еще важнее то, что новый антибиотик не вызывает развития устойчивости к антибиотикам у обработанных штаммов. Отметим, что многократное воздействие антибиотиков может спровоцировать развитие защитных механизмов у некоторых бактерий, что в конечном итоге приводит к развитию устойчивости, что крайне затрудняет лечение инфекций. В ходе исследования ученые провели 28-дневный эксперимент, в котором бактерии E. faecium подвергались воздействию возрастающих концентраций преметиленомицина С-лактона, что создавало идеальные условия для развития резистентности. Однако в результате ученые не наблюдали никаких изменений в минимальной концентрации препарата, необходимой для достижения видимого эффекта. Ученые намерены продолжить исследования, чтобы превратить обнаруженный антибиотик в препарат, который достаточно долго сохраняется в организме, не токсичен для человека и не склонен к развитию резистентности. Кроме того, ученые намерены расширить количество штаммов бактерий, на которые может воздействовать антибиотик. | |
|
|
|
| Комментариев нет. |
|